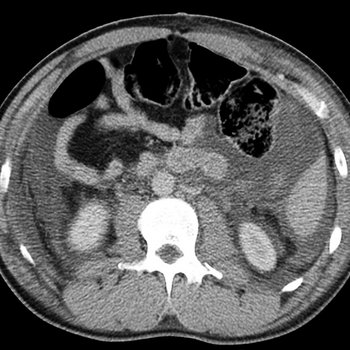
cover art

Paral·lel Festival 2024 ID's
by Sunju Hargun
Track id's from a favourite memory last summer on the mountains of Port del Comte
- Buy
 Seefeel -Warp Records
Seefeel -Warp Records
Sky Hooks - Buy
 Mammo -
Mammo -
Plate - Buy
 2301 -
2301 -
Shell - Buy
 Karenn -
Karenn -
Milk - Buy
 Mathew Jonson -
Mathew Jonson -
Magic Through Music - Buy
 Voal -
Voal -
Saffron - Buy
 Placid Angles -FIGURE
Placid Angles -FIGURE
Cha´kwaina (Marcel Dettmann Remix) - Buy
Cyclic Backwash -
Cyclic Backwash -
Cortex Subduction - Buy
 Gilmer Galibard -
Gilmer Galibard -
Henko (Tapasya Mix) - Buy
 ESHU Records -
ESHU Records -
Lunar Farside (Dimi Angélis & Jeroen Search Remix) - Buy
 Ben Kaczor -
Ben Kaczor -
Lights - Buy
 Kontakt Records -
Kontakt Records -
Julia Sets - Buy
 Save Your Atoll (Remix by Forest On Stasys) -
Save Your Atoll (Remix by Forest On Stasys) -
Azione Antropica - Buy
 Morphing Territories -
Morphing Territories -
Dicephalic Snake - Buy
 Konduku -
Konduku -
Spiracle - Buy
 80xx -
80xx -
Creeper
Embed list